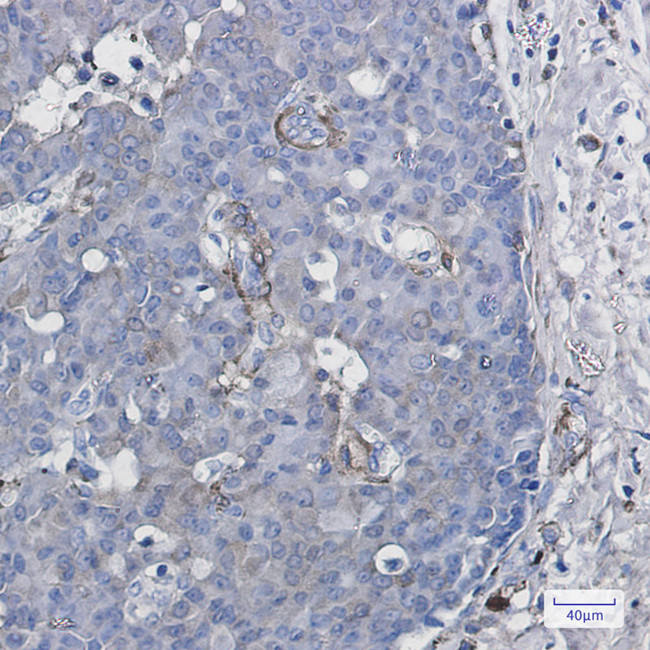
CYP1B1 Antibody in Immunohistochemistry (Paraffin) (IHC (P))

Search
Invitrogen
CYP1B1 Recombinant Rabbit Monoclonal Antibody (K01_1Q09)
{{$productOrderCtrl.translations['antibody.pdp.commerceCard.promotion.promotions']}}
{{$productOrderCtrl.translations['antibody.pdp.commerceCard.promotion.viewpromo']}}
{{$productOrderCtrl.translations['antibody.pdp.commerceCard.promotion.promocode']}}: {{promo.promoCode}} {{promo.promoTitle}} {{promo.promoDescription}}. {{$productOrderCtrl.translations['antibody.pdp.commerceCard.promotion.learnmore']}}
图: 1 / 2
CYP1B1 Antibody (MA563709) in IHC (P)


产品信息
MA563709
种属反应
宿主/亚型
Expression System
分类
类型
克隆号
抗原
偶联物
形式
浓度
规格
纯化类型
保存液
内含物
保存条件
运输条件
RRID
产品详细信息
Immunogen sequence: NHDPLKWPNP ENFDPARFLD KDGLINKDLT SRVMIFSVGK RRCIGEELSK MQLFLFISIL AHQCDFRANP NEPAKMNFSY GLTIKPKSFK VNVTLRESME LLDSAVQNLQ AKETCQ
Highest antigen sequence identity to the following orthologs: Mouse - 78%, Rat - 79%, Pig - 84%, Cynomolgus monkey - 94%.
靶标信息
CYP1B1 is a 543 amino acid intracellular protein localized to the endoplasmic reticulum. It belongs to the cytochrome P450 super family of enzymes which are monooxygenases and it catalyzes many reactions involved in drug metabolism and synthesis of cholesterol, steroids and other lipids. This enzyme metabolizes procarcinogens such as polycyclic aromatic hydrocarbons and 17beta-estradiol and is also involved in the metabolism of substances active in the eye growth and differentiation and hence plays a putative role in ocular development. Mutated proteins are known to cause primary congenital glaucoma.
仅用于科研。不用于诊断过程。未经明确授权不得转售。
篇参考文献 (0)
生物信息学
蛋白别名: aryl hydrocarbon hydroxylase; CYPIB1; Cytochrome P450 1B1; cytochrome P450, family 1, subfamily B, polypeptide 1; cytochrome P450, subfamily 1B, polypeptide 1; cytochrome P450, subfamily I (dioxin-inducible), polypeptide 1 (glaucoma 3, primary infantile); Cytochrome P450RAP; dioxin-inducible cytochrome p450; flavoprotein-linked monooxygenase; Hydroperoxy icosatetraenoate dehydratase; microsomal monooxygenase; P450RAP; unnamed protein product; xenobiotic monooxygenase
基因别名: ASGD6; CP1B; CYP1B1; CYPIB1; GLC3A; P4501B1
UniProt ID: (Human) Q16678, (Rat) Q64678
Entrez Gene ID: (Human) 1545, (Rat) 25426